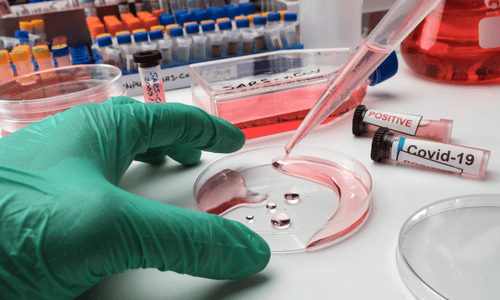

Shaping the Future of Healthcare
Empowering students with world-class medical education and compassionate clinical training.
Years
Students
Qualified
Specialized



KMCH Institute of Health Sciences & Research
KMCH Institute of Health Sciences, Coimbatore is among the most sought-after medical colleges in Tamil Nadu. Established in 2019 under the aegis of Kovai Medical Centre and Hospital Ltd., the institute offers 150 MBBS seats annually.
Guided by its mission to deliver world-class patient care, education, and training, KMCHIHSR focuses on developing highly skilled, competent, and compassionate medical professionals. The campus provides a stimulating learning environment with modern infrastructure, advanced laboratories, and facilities that foster both academic excellence and personal growth.
Our Departments
Explore a wide range of medical and allied health departments, each dedicated to excellence in education, research, and patient care.
Anatomy
The Anatomy course provides an in-depth study of the human body’s structure, helping students build a strong foundation for clinical practice.


Physiology
The Physiology course explores the functions of the human body and providing essential knowledge to understand health and disease.


Biochemistry
The Biochemistry course examines the chemical basis of life, exploring biomolecules and their role in health and disease.


Microbiology
This course provides essential knowledge of microorganisms, their interactions with humans, and their significance in clinical practice.


Pathology
This course equips students with knowledge of disease mechanisms, diagnosis, and the foundation for effective medical treatment.

Pharmacology
Pharmacology bridges science and treatment by studying drug mechanisms, side effects, and clinical applications.


Campus & Infrastructure – KMCH, Coimbatore
The KMCH campus in Coimbatore offers a modern, student-friendly environment designed to support both academic excellence and overall well-being. Spread across spacious grounds, the campus blends cutting-edge medical facilities with serene green spaces, creating the perfect setting for focused learning and personal growth.
Research & Innovation
Advancing medical science through groundbreaking research, innovative practices, and a commitment to discovery.

Bridging Lab-to-Clinic
Emphasis on translational outcomes to improve diagnostics, therapeutics, and policy.

Innovation Culture

Academic Rigor
Modeled Ph.D. programs across nursing, pharmacy, and research foundation affiliates.

At KMCH, Coimbatore, learning extends far beyond the classroom.
At KMCH, Coimbatore, learning extends far beyond the classroom. Our calendar is filled with academic, cultural, and community-focused events that enrich student life and foster all-round development. From medical conferences to cultural fests, every event is designed to inspire, educate, and bring the KMCH community together.
Academic & Professional Events
Sports & Wellness
Cultural & Recreational Activities
Community & Social Outreach
Hear What Our Students Say
Hear from our students about their learning journey at KMCH Institute of Health Sciences and Research. Their experiences reflect our commitment to academic excellence, practical training, and compassionate healthcare education.


Excellent Learning Environment
Priya S
MBBS Student
Practical Training that Builds Confidence
The nursing program here has boosted my confidence and skills. The supportive environment and hands-on clinical training make every day a valuable experience.
Rahul M
B.Sc Nursing Student
Just in Case You Missed Anything.
We offer a wide range of undergraduate, postgraduate, and diploma programs in Medicine, Nursing, Physiotherapy, Allied Health Sciences, and Research.
You can apply online through our official admission portal. The selection process is based on entrance exam scores and eligibility criteria set by the institution.
Yes, we provide separate, fully-equipped hostel facilities for boys and girls with a safe and student-friendly environment.
Students gain hands-on training at KMCH Hospital, one of the leading multi-specialty hospitals in the region, ensuring practical learning alongside academics.
Yes, KMCH IHSR has a dedicated research department that encourages students to participate in innovative projects, seminars, and national-level conferences.


Insights & Updates
Stay updated with news, student stories, research highlights, and academic insights from KMCH-IHSR

